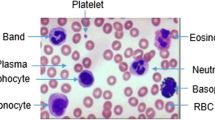

Abstract
Peripheral blood smear analysis is a gold-standard method used in laboratories to diagnose many hematological disorders. Leukocyte analysis helps in monitoring and identifying health status of a person. Segmentation is an important step in the process of automation of analysis which would reduce the burden on hematologists and make the process simpler. The segmentation of leukocytes is a challenging task due to variations in appearance of cells across the slide. In the proposed study, an automated method to detect nuclei and to extract leukocytes from peripheral blood smear images with color and illumination variations is presented. Arithmetic and morphological operations are used for nuclei detection and active contours method is for leukocyte detection. The results demonstrate that the proposed method detects nuclei and leukocytes with Dice score of 0.97 and 0.96 respectively. The overall sensitivity of the method is around 96%.








Similar content being viewed by others
References
Kose, K., Cetin-Atalay, R., and Cetin, E., A, Special issue on microscopic image processing. SIViP 8(1):1, 2014.
Hiary, H., Alomari, R. S., Saadah, M., and Chaudhary, V., Automated segmentation of stromaltissue in histology images using a voting Bayesian model. SIViP 7(6):1229, 2013.
Jyoti, R., Annapurna, S., Bhadauria, H., Jitendra, V., and Jagtar Singh, D., Computer assisted classification framework for prediction of acute lymphoblastic and acute myeloblastic leukemia. Biocybernetics and Biomedical Engineering 37(4):637, 2017.
Enas, A., Mazin Abed, M., Dheyaa Ahmed, I., Arunkumar, N., and Venkatraman, V., Computeraided solution for automatic segmenting and measurements of blood leucocytes using static microscope images. J. Med. Syst. 42(4):58, 2018.
Der-Chen, H., Kun-Ding, H., and Yung-Kuan, C., A computer assisted method for leukocytenucleus segmentation and recognition in blood smear images. The Journal of Systems and Software 85:2104, 2012.
Madhloom, H. T., Kareem, S. A., Ariffin, H., Zaidan, A. A., Alanazi, H. O., and Zaidan, B. B., An automated white blood cell nucleus localization and segmentation using image arithmetic and automatic threshold. J. Appl. Sci. 10(11):959, 2010.
Lorenzo, P., and Di Cecilia, R., White blood cells identification and counting from microscopicblood image. International Journal of Medical, Health, Biomedical, Bioengineering and Pharmaceutical Engineering 7(1):20, 2013.
Yiping, Y., Yiping, C., and Wenxian, S., A method of leukocyte segmentation based on S component and B component images. Journal of Innovative Optical Health Sciences 7(1):1, 2014. https://doi.org/10.1142/S1793545814500072.
Leyza Baldo, D., Rodrigo, M., and Neucimar Jeronimo, L., White blood cell segmentation using morphological operators and scale-space analysis. In Proceedings of IEEE XX Brazilian Symposium on Computer Graphics and Image Processing pp. 294–304, 2007. https://doi.org/10.1109/SIBGRAPI.2007.33
Yan, L., Rui, Z., LeiMi, C., and Di Yihui, Y., Segmentation of white blood cell from acutelymphoblastic leukemia images using dual-threshold method. Computational and Mathematical Methods in Medicine 2016:1, 2016.
Syadia Nabilah, M. S., Mohd Razali, M. T., and Wan Nurshazwani, W. Z., White blood cell (WBC) counting analysis in blood smear images using various color segmentation methods. Measurement 116:543, 2018.
Minal, D. J., Karode, A. H., and Suralkar, S. R., Detection of acute leukemia using white bloodcells segmentation based on blood samples. International Journal of Electronics and Communication Engineering and Technology 4:148, 2013.
Nagabhushana, R. M., and Rajeshwari, P., Geometrical analysis of leukocyte nucleus to detect lymphoblast from microscopic blood images. International Journal of Technology and Engineering Science 2(6):1947, 2014.
Mazin, Z. O., and Alaa, B. A., Segmentation and feature extraction of lymphocytes WBC using microscopic images. International Journal of Engineering Research and Technology 3:696, 2014.
Nemane, J. B., Chakkarwar, V. A., and Lahoti, P. B., White blood cell segmentation and counting using global threshold. International Journal of Emerging Technology and Advanced Engineering 3:639, 2013.
Hayan, T. M., Sameem Abdul, K., and Hany, A., An image processing application for thelocalization and segmentation of lymphoblast cell using peripheral blood images. J. Med. Syst. 36:2149, 2012. https://doi.org/10.1007/s10916-011-9679-0.
Ramin, S., Hossein, R., and Ardeshir, T., Extraction of nucleolus candidate zone in white bloodcells of peripheral blood smear images using curvelet transform. Computational and Mathematical Methods in Medicine 2012:1, 2012.
Sajjad, M., Khan, S., Jan, Z., Muhammad, K., Moon, H., Kwak, J. T., Rho, S., Baik, S. W., and Mehmood, I., Leukocytes classification and segmentation in microscopic blood smear: A resource-aware healthcare service in smart cities. IEEE Access 5:3475, 2017.
Narjes, G., Alireza, V., Ardeshir, T., and Pardis, N., Segmentation of white blood cells from microscopic images using a novel combination of k-means clustering and modified watershed algorithm. Journal of Medical Signals and Sensors 7(2):92, 2017.
Zhi, L., Jing, L., Xiaoyan, X., Hui, Y., Xiaomei, L., Jun, C., and Chengyun, Z., Segmentation ofwhite blood cells through nucleus mark watershed operations and mean shift clustering. Sensors (Basel) 15(9):1, 2015.
Congcong, Z., Xiaoyan, X., Xiaomei, L., Ying-Jie, C., Wu, Z., Jun, C., Chengyun, Z., and Zhi, L., White blood cell segmentation by color-space-based k-means clustering. Sensors (Basel) 14(9):16128, 2014. https://doi.org/10.3390/s140916128.
Morteza Moradi, A., Saeed, K., Ardeshir, T., and Mostafa Ghelich, O., Recognition of acute lymphoblastic leukemia cells in microscopic images using kmeans clustering and support vector machine classifier. Journal of Medical Signals and Sensors 5:49, 2015.
Lin, Y., Peter, M., and David, J. F., Unsupervised segmentation based on robust estimation andcolor active contour models. IEEE Trans. Inf. Technol. Biomed. 9(3):475, 2005.
Seyed Hamid, R., and Hamid Soltanian, Z., Automatic recognition of five types of white bloodcells in peripheral blood. Comput. Med. Imaging Graph. 35:333, 2011.
Farnoosh, S., Zainina, S., Abdul Rahman, R., Badrul Hisham, A. K., and Iqbal, S. M., A framework for white blood cell segmentation in microscopic blood images using digital image processing. Biological Procedures Online 11:196, 2009. https://doi.org/10.1007/s12575-009-9011-2.
Byoung Chul, K., Ja-Won, G., and Jae-Yeal, N., Automatic white blood cell segmentation usingstepwise merging rules and gradient vector flow snake. Micron 42(7):695, 2011.
Mathur, A., Tripathi, S. A., and Kuse, M., Scalable system for classification of white blood cellsfrom leishman stained blood stain images. Journal of Pathology Informatics 4(Suppl):S15, 2013. https://doi.org/10.4103/2153-3539.109883.
Donida, R., Labati, V. and Piuri, F. S., ALL-IDB: The acute lymphoblastic leukemia image database for image processing, pp. 2045–2048, 2011. https://doi.org/10.1109/ICIP.2011.6115881
Magorzata, P., Juliusz, L. K., and Diana, W., Biomedical images enhancement based on theproperties of morphological spectra. Biocybernetics and Biomedical Engineering 35(3):206, 2015.
Bakos, M., Active contours and their utilization at image segmentation. Poprad: Proc. 5thSlovakian-Hungarian Joint Symposium on Applied Machine Intelligence and Informatics, 2007, 313–317.
Kass, A. W. D. T., M., Snakes: Active contour models. International Journal of ComputerVision 1(4):321, 1988.
Keerthana, P., Jan, W., Bhagath, P., Kumar, C., Marx, P., and Gopalakrishna, K., Applications ofTissueQuant a color intensity quantification tool for medical research. Comput. Methods Prog. Biomed. 106(1):27, 2012.
Rong, C., Xiaoqin, Z., Lixin, H., and Min, W., Subimage cosegmentation in a single white bloodcell image, Proceedings of IEEE 7th International Conference on Computational Intelligence, Communication Systems and Networks pp. 152–157, 2015. DOI https://doi.org/10.1109/CICSyN.2015.36
Author information
Authors and Affiliations
Corresponding author
Ethics declarations
Funding
No funding was used for the proposed work.
Conflict of interest
The authors declare that they have no conflict of interest.
Additional information
Publisher’s Note
Springer Nature remains neutral with regard to jurisdictional claims in published maps and institutional affiliations.
This article is part of the Topical Collection on Image & Signal Processing
Rights and permissions
About this article
Cite this article
Hegde, R.B., Prasad, K., Hebbar, H. et al. Image Processing Approach for Detection of Leukocytes in Peripheral Blood Smears. J Med Syst 43, 114 (2019). https://doi.org/10.1007/s10916-019-1219-3
Received:
Accepted:
Published:
DOI: https://doi.org/10.1007/s10916-019-1219-3